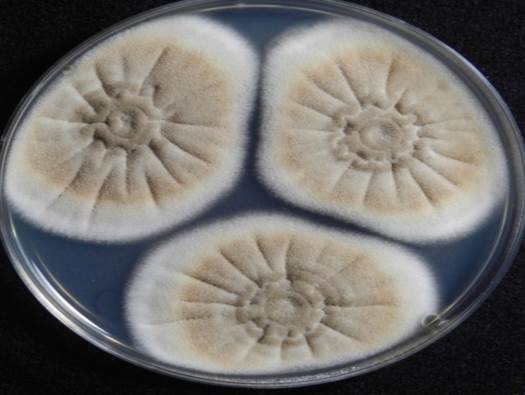
KACC 46516 배양 사진.jpg

막걸리를 만드는 백국균은 어디에서 왔을까?
곰팡이 이야기 1
술은 온전히 곰팡이가 빚은 음료이다. 효모는 하나의 포도당을 먹고는 두분자의 이산화탄소와 두분자의 알코올을 만들어 낸다. 그래서 포도당이 주요성분인 포도는 항아리에 담아 으깨놓기만 해도 술이 된다. 효모는 사방에 지천으로 있기 때문이다.
하지만 쌀로 술을 만들려면 쌀의 주성분인 전분을 먼저 포도당으로 만들어야 하는데(포도당化, 糖化) 이 역할을 하는 것이 누룩곰팡이다. 곰팡이는 입이 없어서 피부로 영양소를 흡수하는데 전분은 너무 커서 흡수할 수 없고 포도당으로 잘게 부셔야 피부로 흡수할 수 있다. 곰팡이는 큰 영양분을 잘게 자르는데 효소라는 도구를 사용한다. 누룩곰팡이는 자기가 먹기 위하여 쌀의 전분을 포도당으로 자르는 효소를 대량 방출하는데 이것이 술 제조에는 매우 중요하다.
전통적으로 우리조상들은 밀을 이용하여 덩어리누룩(甁麴)을 만들었다. 밀을 거칠게 빻아서 물과 함께 뭉쳐 놓으면 곰팡이에겐 먹기 좋은 떡이다. 함께한 초재나 주변 공기의 곰팡이들이 밀에서 자라면서 당화효소를 분비하는데 이것이 고두밥의 전분을 포도당으로 분해하고 이 포도당은 효모가 알코올을 만드는데 사용된다. 이렇게 밀을 미끼로 하여 풀이나 공기 중의 곰팡이를 모셔서 당화를 시킬 효소를 만들게 하는데 입맛이 까다로운 곰팡이를 키우는 일이 쉬운 일만은 아니었다. 때로는 조건만 맞으면 20분마다 한 세대의 후손을 만드는 세균이 밀을 먼저 차지하여 술을 오염시키기도 하고 때로는 당화력도 없는 곰팡이 들이 밀을 차지하여 술을 망치기도 하였다.
일제강점기에 일본으로부터 술을 잘 만드는 곰팡이를 골라서 키워 놓은 흩임누룩(粒麴)이 들어오게 되는데 곡자에 비하여 술을 만들기도 쉽고 실패할 가능성도 낮아서 우리나라 술 제조에 많은 영향을 주게 되었다. 현재에 우리나라의 소주와 막걸리 만드는 데에 주로 이용되는 입국 중의 하나인 백국균(白麴菌)의 유래에 대하여 정리해보고자 한다.
백국균의 유래
이 균을 이야기하려면 유구(琉球)의 아와모리 소주부터 이야기해야 한다. 먼저 유구제도부터. 유구제도는 동중국해의 대만과 일본의 가고시마 사이에 펼쳐진 섬들을 일컫는다. 1879년에 일본이 강제로 차지하기 전까지는 동남아, 중국, 조선, 일본 등과의 중계무역으로 번성한 독립왕국 유구국(琉球國)이 있었고 2차 세계대전 후에는 미군정이 통치하다가 일본에 반환된 것은 50여년 전인 1972년이다. 비록 현재는 일본의 오키나와 현으로 포함되어 있지만 유구제도가 일본의 영토인 기간은 채 100년에 불과하다.

<유구제도, 위키피디아 인용>
아와모리주(砲盛酒)는 유구에서 쌀에 검은누룩(黑麴)을 넣어 발효하고 1차 증류한 증류주이다.
유구국은 14세기에 태국으로부터 술 증류기술을 들여오는데 여기에 유구 기후에 최적인 검은누룩곰팡이(黑麴菌)를 더해서 특유의 소주를 만들었다. 유구국은 이 특산 소주를 명나라, 조선, 일본 등에 진상하였는데 조선왕조 실록에 '1460년에 유구국은 세조에게 천축주(天竺酒)를 진상하였다'는 기록이 있다. 또한 '1478년에 조선 백성이 표류하다가 유구국에 도착하였는데 유구 사람들이 남만주(南蛮酒)라는 술을 마셨는데 그 맛이 조선 소주와 유사하다'라는 기록이 있다. 이 소주는 유구주(琉球酒), 소주(燒酎) 등으로 불렸는데 15세기부터 19세기까지 일본에 이 소주를 진상하면서 일본에서는 기존의 일본의 가고시마산 소주와 이 유구소주를 구분하기 위하여 아와모리주(泡盛酒)라는 이름을 사용하게 되었다. 즉 아와모리주는 유구산 소주에 대한 일본인 측면의 호칭으로 시작하였다.
1879년 유구제도가 일본에 합병되고 일본 학자들은 유구 특산 소주, 아와모리주에 관심을 가지게 된다. 1901년에 동경대학교 대학원생인 이누이(乾環)는 오키나와의 아와모리주를 만드는 특유의 흑색누룩(黑麴)으로부터 곰팡이(KACC 46772, KACC - Korean Agricultural Culture Collection, 농업미생물은행)를 분리하고 Aspergillus luchuensis (유구산 아스페르길루스, luchu는 유구의 영어식 발음)라 이름 지었다(1). 같은 해 일본 우사미(宇佐美)씨도 아와모리 흑국으로부터 곰팡이를 분리하였는데(NBRC 4314) 흑국의 주요 균은 이누이가 보고한 A. luchuensis라고 기록하였다(2).
유구소주에 관심을 가진 것은 학자들만이 아니었다. 장류(醬類) 양조 가문에서 태어난 가와치(가와치 켄이치로, 河內源一郞 1883-1948)씨는 가업이 부진하자 1909년에 26세의 나이로 가고시마의 양조장 기술지도원으로 입사한다(3). 당시의 양조장 기술지도원은 대장성 공무원이었다. 가고시마는 여름철의 기온이 높고 습한데 가와치씨가 지도하는 양조장에서는 여름철에 소주 모로미가 부패하여 소주 제조에 어려움을 겪었다. 이에 가와치씨는 더운 지역인 가고시마에서 소주를 만드는데 한냉지에서 일본주를 만드는 황국균을 사용하는 것이 문제라고 판단하고 훨씬 이남 오키나와의 아와모리 흑국에 관심을 가졌다.
가와치씨는 오키나와로부터 아와모리 흑국균을 도입하고 각고의 노력 끝에 가고시마 소주에 적용시키는데 성공한다(1910). 아와모리 흑국균은 기존의 황국균에 비하여 당화력이 높아 소주 생산량이 많고 무엇보다도 구연산을 생성하여 세균 오염을 막기 때문에 술을 안정적으로 생산할 수 있었다. 가와치씨는 양조업자들에게 흑국균의 사용을 적극 권장하였는데 그의 열성적인 기술지도로 가고시마의 대부분의 양조업자는 흑국균을 사용하게 되었다. 이로써 가고시마의 소주 산업도 비약적으로 발전하게 된다.
한편 1911년에 나카자와(中澤)씨는 유구와 대만의 소주 흑국으로부터 곰팡이를 분리하고는(KACC 47234) 이누이가 보고한 균주와는 서로 다른 종이라 하여 Aspergillus awamori (아와모리 Aspergillus)라 이름 붙였다. 이누이가 보고한 균주는 포자를 방출하는 경자가 단층인데 본인이 분리한 균주는 복층이라는 것이었다. 학자들은 이 관점에서 기존에 분리한 흑국균을 다시 관찰하였는데 모두가 복층의 경자를 가지고 있었기 때문에 A. awamori라는 이름이 A. luchuensis를 대체하기 시작하였다.
양조업자인 가와치씨는 곰팡이의 이름보다는 소주를 잘 만드는 곰팡이가 중요하였다. 1924년 어느 날 보존되어 있던 흑국균의 일부포자가 회백색으로 바뀐 것을 발견하고는 이들을 순수 분리하여 소주 제조에 사용하여 보았다. 그 결과 기존 흑국균에 대비하여 종국 제조가 용이하였고 특히 고구마 소주 제조에 적합하였다. 무엇보다도 흑색 곰팡이를 이용하였을 때에 작업장이 검게 오염되는 문제점을 해결할 수 있었다. 가와치 씨는 이 균을 흑국균에 대비하여 백국균(白麴菌)이라 칭하고 아와모리 Aspergillus의 변종이라 하여 Asp. awamori var. kawachii로 학계에 보고하였다. 하지만 일본 학계에서는 크게 주목하지 않았고 양조업자들 또한 흑국균으로 이미 소주 제조가 안정화 단계에 있었으므로 백국균을 곧바로 사용하지는 않았다(3).

< 일본인 양조업자 Kawachi 씨가 개발한 균주 KACC 46516, PLoS ONE 인용>
가와치씨는 1931년에는 공무원을 그만두고 가와치겐이치로 상점을 열고 본격적으로 종국의 개발과 판매에 뛰어 든다. 열성적으로 백국균에 대하여 홍보하고 기술지도 한 덕분에 백국균은 먼저 북구주의 소주 제조에 이용되고 이어 조선, 만주 및 일본에 사용되게 된다. 이에 경도대학교의 기타하라(北原) 교수는 백국균에 주목하고 이들에 대하여 연구 후에 백국균을 Asp. awamori var. kawachii에서 새로운 종인 Aspergillus kawachii로 명명한다. 가와치씨가 작고한 1년 뒤인 1949년의 일이다.
백국균이 언제 우리나라에 들어왔는지는 명확하지는 않으나 기타하라(北原) (1949)교수의 문헌에 의하면 백국균이 이 때에 한국에서 유통된다는 기록이 있다. 그 사이의 경위는 더 조사가 필요하지만 1970년대에는 막걸리와 희석식소주를 제외한 전통소주 생산에는 대부분 백국균이 사용되었다(희석식 소주가 대중화되기 전인 1960년대에는 소주가 성행하였는데 이 때는 오히려 우사미, 시로우사미 등의 흑국균이 많이 이용되었다고 한다, 도종호). 이후 1990년들어 전통술에 대한 의식이 높아지면서 덩이누룩(餠麴)에 대한 연구가 활성화되고 전통누룩이 확대 사용되고 있지만 아직 우리나라의 소주와 막걸리 생산에서 백국균이 차지하는 비중은 매우 크다.
(한국으로의 백국균의 도입과 이의 확장에 대하여는 실제 이를 제조 공급하였거나 공급하고 있는 효자종국의 이두영, 아시아종국의 정종욱, 수원발효의 도종호 님의 증언을 바탕으로 후에 정리하고자 한다.)
백국균의 학명
처음 가와치(河內)씨는 유구(琉球)로부터 흑국균을 도입하고 Aspergillus niger var. awamori로 명명하였다. 하지만 흑국균의 돌연변이 백국균을 발견한 1924년에는 흑국균에 대하여 A. awamori라는 이름이 더 일반적이었으므로 백국균을 A. awamori var. kawachi라 명명하였고 경도대학교 기타하라 교수는 이를 A. kawachi로 승격 시켰다.
최근의 유전자염기서열 분석을 통하여 이누이씨의 KACC 46772 (A. luchuensis), 우사미 씨의 NBRC 4314 (A. luchuensis), 나카자와 씨의 KACC 47234 (A. awamori), 카와치씨의 KACC 46771 (A. kawachii)가 모두 같은 종임이 입증되었다. 이 경우에는 먼저 보고된 종을 바른 이름으로 한다는 국제적인 원칙에 따라 이들은 모두 Aspergillus luchuensis로 명명되었다. 다만 백국균의 경우에는 용도가 많고 다른 균들과 색깔로 구분되기 때문에 사용의 편리성을 위하여 유구산 아스페르길루스에 더하여 돌연변이종 kawachii를 붙인 Aspergillus luchuensis mut. kawachii를 사용하여도 된다(4).

< 흑국균의 이름변화, Applied Microbiology and Biotechnology(5) 인용>
한국 토종 백국균의 개발
백국균(흑국균 포함)은 술 제조에 큰 장점이 있다. 초기 술 발효 시에 구연산을 생성하여 pH를 3까지 떨어뜨려서 오염균인 세균의 발생을 막아 안정적으로 술을 생성할 수 있다. 또한 구연산의 신맛은 술맛의 청량감을 더할 수 있다. 이러한 장점으로 백국균은 우리나라의 막걸리와 소주 제조에 많이 이용되게 되었다. 하지만 이 곰팡이가 1) 일본 양조업자에 의하여 분리되고 한국으로 전파되었다는 점에서 2) 또한 청주를 만드는 술이 아닌 증류주인 소주를 만드는 곰팡이라는 점에서 거부감을 가질 수 있다. 이에 우리나라의 술 제조에 있어 백국균에 대한 의존율을 낮출 필요성이 있다.
그렇다고 해서 백국균으로 만든 술을 폄하하거나 부정적으로 받아들일 필요는 없을 것으로 생각된다. 우리가 이 곰팡이를 일본에서 유래하였기에 부정적인 시각으로 바라본다면 일본도 이 백국균을 부정적인 시각으로 보아야 한다. 왜냐면 백국균의 원균은 일본 전통소주 제조에서 온 균이 아니라 태국에서 유래한 유구소주를 만드는 유구국(琉球國)에서 들여온 곰팡이 균주를 사용하였기 때문이다.
그럼에도 불구하고 우리나라 술인 막걸리를 일본인 양조업자가 공급한 것으로 만든다는 것에 대하여 자존심이 상한다면 우리나라산 백국균을 개발하면 어떨까?
백국균은 흑국균 Aspergillus luchuensis의 백색돌연변이주이다. Aspergillus luchuensis는 술을 만드는 데에만 쓰이는 것이 아니라 중국의 보이차를 발효시키는 원인균이기도 하고 우리나라 메주에서도 자주 분리된다. 필자가 메주에서 분리한 54균주의 검은색 아스페르길루스 중에서 14균주가 Aspergillus luchuensis였다(6). 누룩에서 아직 분리하였다는 보고는 접한 적이 없지만 고온으로 발효한다는 점에서 보면 충분히 많이 존재할 수 있다(황국의 생육적온은 31도씨, 흑국균의 생육적온은 34도씨). 또한 검은 아스페르길루스의 백색 돌연변이주는 흔치는 않지만 종종 발생한다. 마치 젊은이들의 머리카락에 새치가 나는 것처럼. 필자 역시 흑국균의 자연 배양 시에 백색 돌연변이를 관찰한 적이 있다.
< 토종 메주에서 분리한 Aspergillus luchuensis KACC 46490, 흑색곰팡이지만 돌연변이를 유발시켜 백국균을 만들 수도 있다>
그렇다면 우리나라에서 유래한 토종백국균을 개발하면 어떨까? 메주와 전통 누룩 등에서 Aspergillus luchuensis를 다수 선발하고 이 중에서 발효 특성이 우수한 균주를 골라 UV등을 조사하여 백색변이주를 선발하면 된다. 이는 기술적으로 어렵지 않은 것이다. 기존의 가와치백국균의 사용도 문제는 없지만 우리나라 술 막걸리의 자존심 향상을 위하여 그리고 술 맛의 다양화를 위하여 한국 토종백국균을 개발하는 것도 좋은 방안으로 생각된다.
<참고문헌>
1) 乾環. 琉球泡盛酒醱酵菌調査報告 (官報), 工化, 4:1357-61. (1901).
2) 宇佐美柱一郞. 泡盛酒釀造硏究報告, 工化, 4:1437-61. (1901).
3) 河内源一郎 - Wikipedia. https://ja.wikipedia.org/wiki/%E6%B2%B3%E5%86%85%E6%BA%90%E4%B8%80%E9%83%8E
4) Hong SB et al., Aspergillus luchuensis, an industrially important black Aspergillus in East Asia. PLoS One 8, e63769 (2013)
5) Hong SB et al., Taxonomic reevaluation of black koji molds. Applied Microbiology and Biotechnology. 98: pp 555–561 (2014)
5) 홍승범 등. 메주에서 분리한 검은 Aspergillus 균주의 동정. 한국균학회지, 41:132-5. (2013)
<용어 설명>
흑국균(黑麴菌): 소주 발효에 이용되는 검은색 Aspergillus 곰팡이. 예전에는 다양한 곰팡이 종이 흑국균으로 불렸으나 최근에 Aspergillus luchuensis, A. tubingensis, A. niger의 3종으로 정리되었다(참고 1. 흑국균의 학명 변화). 이 중 A. luchuensis가 주요균이므로 좁은 의미의 흑국균은 A. luchuensis 만을 의미한다. 황국균에 비하여 구연산 생성력이 강하여 술 발효시에 세균 오염이 적고 Glucoamylase 효소를 많이 생성하여 생전분 분해도 가능하다. A. luchuensis와 A. tubingensis는 곰팡이독소, 오크라톡신을 생성하지 않지만 A. niger의 일부 곰팡이는 오크라톡신을 생성할 수 있다.
백국균(白麴菌): 흑국균, A. luchuensis의 백색돌연변이주로 이를 흑국균과 구분할 때에는 Aspergillus luchuensis mut. kawachii로 기록한다. 백국균은 다수의 균주들에 대한 그룹이 아니고 KACC 46771의 단일균주에 대한 이름이다. 때로 Aspergillus oryzae의 백색 돌연변이주와 A. niger의 백색돌연변이주인 A. shirousami도 백국균으로 불린다.
황국균(黃麴菌): 미소와 청주를 만드는 Aspergillus oryzae, 간장을 만드는 Aspergillus sojae가 황국균에 속한다. 배지에 배양 시에는 실제 황색보다는 연두색에 가깝다.